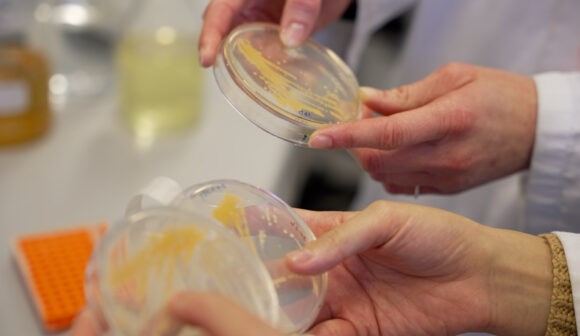

Meet the spin-outs
Meet the researchers behind the diverse portfolio of spin-outs or future companies working to solve societal challenges.
Meet the researchers behind the diverse portfolio of spin-outs or future companies working to solve societal challenges.
55 spin-outs have been admitted to the program. Below you will find a selection of projects, more will be added as the Spin-outs Denmark program continues

New medical device enabling heart valve repair instead of replacement

Laser-based open-path sensors for real-time greenhouse gas emission monitoring

Empowering small businesses with scalable Digital Twin technology

Digital Infrastructure for Interpreting Quality Control in the AI Era

Engineering naturally water-repellent fungal leather for sustainable fashion innovation.

Helping screenwriters integrate sustainability into narratives via innovative storytelling

Biofabricating ethical and sustainable real leather using animal stem cells

Helps clinicians advance mental health care with next-gen learning & assessment technologies.

Cell assay for predicting the risk of cancer recurrence.

Bringing the world’s highest quality 2D nanomechanical resonator to the real world.

Develops the next generation of biopesticides using consortia of bacteria, called collaboromes.

Bioprinting platform using light to fabricate 3D tissue in under 30 seconds.

A Cyber Threat Intelligence system able to mine and analyze data from heterogeneous sources (e.g. darkweb).

Measuring authenticity and identifying regional factors for hot and trendy brands

A radically new technology for real-time monitoring of small molecules in biosolutions.

Empowering recovery through motivation
Unlocking the deep sea treasure chest

Bioproduction of biological nitrification inhibitor (BNI) for a more sustainable agriculture.

Rapid food-safety monitoring for the future food industry

Hybrid magnetic core for on-board charger in electric vehicle

Device for women suffering from urinary incontinence

Integrated tunable lasers for compact and effective sensing and communication in the mid-infrared.

Data Tools and Services for Worker Advocacy.

A technology company that develops mobile concrete 3D printers for the construction industry.

Boosting the outdoor durability of local wood through upcycled paper industry waste.

Eradicate forever chemicals using green and low-cost photochemistry

A fully automatic wearable device that preserve muscle mass and enhance recovery during hospitalization.

Enhancing crop resilience and yield using plant peptide hormones for sustainable agriculture.

OncoMargin aim to bring certainty to breast cancer surgery, by reducing the number of recurrent operations.

Safeguarding future power grids

Gate driving solutions for grid-connected converter

A software solution that streamlines the film industry’s casting shortlisting process.

A wearable neural interface for natural gesture control

CO₂-powered textile recycling

IC Optimize develops optimization tools for integrated circuit (IC) design to improve time-to-market and reliability of electronics.

Pioneering Sustainable Plant Proteins

Unobtrusive Vital Signs Monitoring

Where green energy meets reliability

We deliver the design and core technology for efficient reforming of CO2 into renewable fuels and chemicals.

Safeguarding global agriculture with targeted insect pest control

Drone technologies for the grid of tomorrow.

Miniaturizing your chargers for a greener, more efficient, and lighter future.

Customised biofertilisers to boost legume crop yields.

Ground investigation data you can trust

Creating adaptable solutions for virtual machine development

Magnetizing a sustainable future

Unlocking efficiency through data compression

Powering low power devices from household light

Revolutionizing high-speed connectivity for a greener, faster tomorrow

Empowering voices with virtual reality

NitroVolt is developing an on-the-farm sustainable ammonia production unit

An Ultrapure Water (UPW) Solution for Offshore Green Hydrogen Production

Autonomous drone systems for continuous monitoring of critical infrastructure

Democratizing micro-/nanoscale 3D printing for mass-customization
Do you have a research project with commercial potential that would be at home among all these? The Spin-outs Denmark program could be for you.